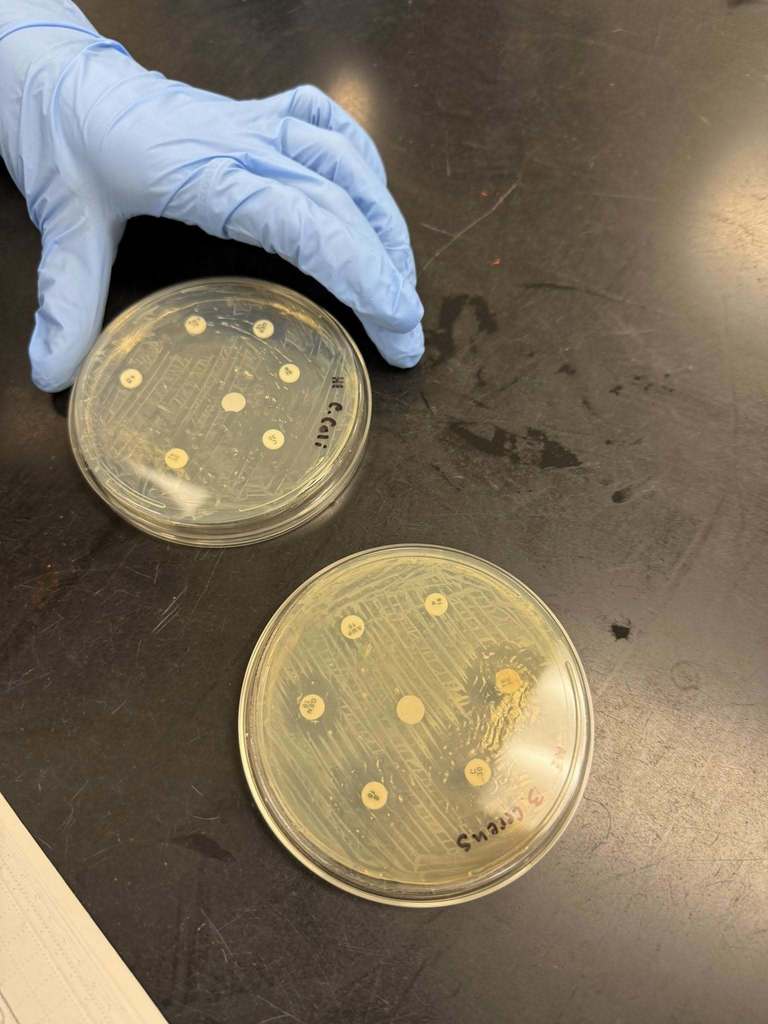
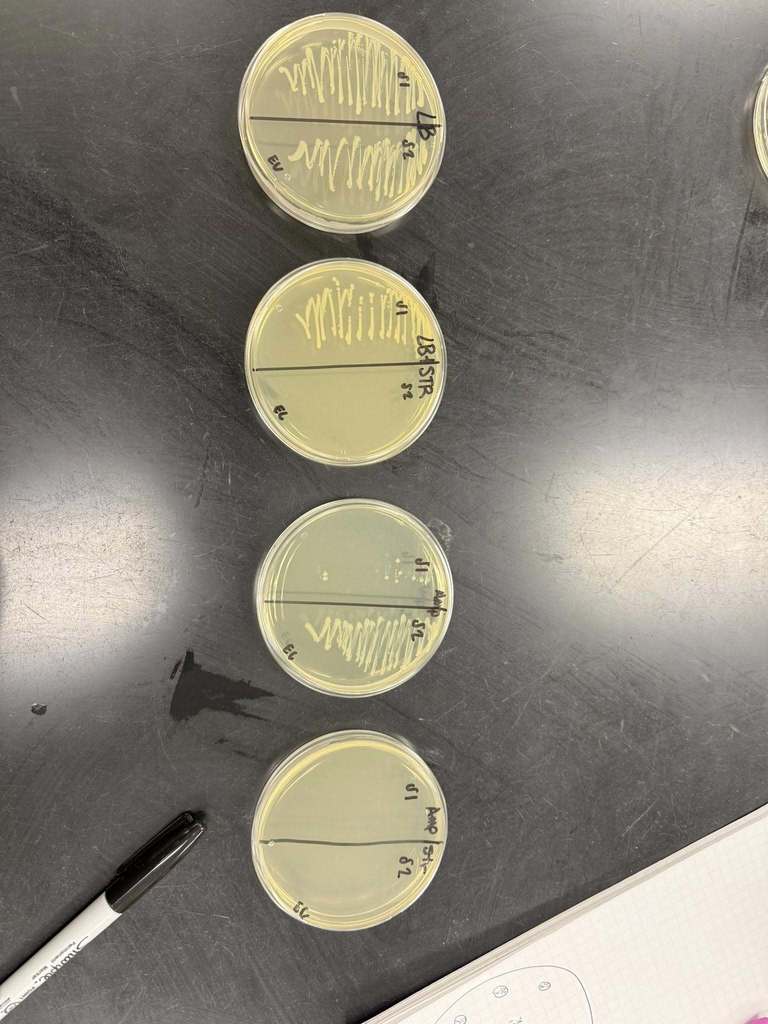

Senior portrait makeup pictures will be tomorrow, October 16th. Pictures will be in the Gym during school. Students will be called out of class by announcment.

Battle of West Mobile! Tickets for the football game against Baker are now available on gofan.co. ALL students must have some form of ID, this can include school ID, Permit, or Drivers License. ALL middle school students must be accompanied by a parent/guardian. Gates will open Friday at 5:30 PM
Regular safety rules still apply:
*Clear Bags
*No re-entry
*No Outside food and drink
*No Changing sides
*No loitering behind bleachers
*Do not bring yard games or sporting equipment
Regular safety rules still apply:
*Clear Bags
*No re-entry
*No Outside food and drink
*No Changing sides
*No loitering behind bleachers
*Do not bring yard games or sporting equipment

Congratulations to Blakely Stringer for being recognized as WKRG's Scholar Athlete of the Week. Blakely is part of our Lady Vikings volleyball team. Thanks to United States Sports University for recognizing Scholar Athletes. Be sure to tune in tonight, October 8th, at 4 PM to see the scholar athlete segment on WKRG News 5. 🏐🖤🩵





Parents, you are invited to "Doughnuts with Diaz" on Tuesday, October 21, 2025 to kick off National Parenting Week! Mr. Diaz will be available to share his thoughts on topics that are a part of his vision for the school as well as a Q & A session. The meeting will be held in the Collab Lab from 9:15 - 9:45 A.M. We look forward to seeing you there!

Today is the day you have all been waiting for.......Fall Plant Sale! We open today but will have to be closed tomorrow. We will re open on Wednesday. click through the pictures for more details and price list. Horticulture will not be able to receive phone calls today so just come out between 8 and 2 to check it out. 🥦🥬🌼🌱🌿🌾






Dr. Mcinnis Academy of Biomedical students in the Medical Interventions class wrapped up their antibiotic resistance assays and conjugation tests this week. 🧫
This lab is one that’s especially meaningful to Dr. Mcinnis. Antibiotic-resistant bacteria are extremely dangerous, and she has seen the impact firsthand. She is so proud of how her students engaged with this important real-world topic and applied their learning in the lab. #CTE
This lab is one that’s especially meaningful to Dr. Mcinnis. Antibiotic-resistant bacteria are extremely dangerous, and she has seen the impact firsthand. She is so proud of how her students engaged with this important real-world topic and applied their learning in the lab. #CTE

Today was jam-packed with learning (and a little chocolate)! 🍫
Dr. McInnis’s Physics and Environmental Science students got a hands-on refresher in basic statistics. Each student received a pack of M&Ms and put their data skills to the test—counting, sorting, and calculating to see if the colors and quantities matched what the company claims is in every bag.
Who knew statistics could be so sweet!
Dr. McInnis’s Physics and Environmental Science students got a hands-on refresher in basic statistics. Each student received a pack of M&Ms and put their data skills to the test—counting, sorting, and calculating to see if the colors and quantities matched what the company claims is in every bag.
Who knew statistics could be so sweet!







Mrs. Nease's' ceramics students will be selling handmade ceramic artwork at MGM’s Annual Spookfest event. The students have dedicated four weeks to creating a variety of pieces, including pumpkins, ghosts, and witch hats, which will be available for purchase. We invite you to stop by the sales table after enjoying the festivities and experience the students’ craftsmanship. Spookfest is October 11th 7-11PM and October 12th 7-9PM. Tickets can be purchased on gofan for $10 or $12 cash at the door.










MCPSS is offering a school-based FLU vaccine clinic through Health Hero for MGM students on October 9, 2025. This is an excellent opportunity to get your child up to date on their FLU vaccine. This service is offered at no cost to you, the parent or guardian. Current health care laws, however, require HNH (Health Hero) to bill the private insurance or Medicaid for the vaccine. There is no cost to you if your child does not have health insurance. Please note: PEEHIP insurance does not cover vaccines under this program. Complete the form and return it to the nursing office before 9 AM on October 8.
Date of Vaccine: Thursday Oct. 9, 2025
Form Due in Nursing Office: Wednesday Oct 8, before 9 am



Attention SENIORS! This week is Free College App Week. Ms. Gillman will be visiting the seniors in their classes to assist them in submitting applications. We are excited to see all their hard work pay off!


Our Lady Vikings Volleyball team will be at home tonight for Senior night. Come cheer on the JV team at 4:30 and Varsity at 5:30!


Our ag students have been putting in a lot of hard work these past few weeks—cleaning, organizing, learning about safety, and taking inventory—to lay the groundwork for a successful year ahead. 🌱💪
We’re excited to kick off plant sales October 13! It’ll still be a little early for fall flowers, and our veggies will just be getting started, so inventory will be limited on broccoli, cauliflower, collards, mustard, and cabbage.
But don’t worry—we’ll have plenty of pansies, mixed pots, perennials, dianthus, and snapdragons to add some color and life to your fall gardens.
Stay tuned for more updates as we get closer to sale time—we can’t wait to see you at the greenhouse!
We’re excited to kick off plant sales October 13! It’ll still be a little early for fall flowers, and our veggies will just be getting started, so inventory will be limited on broccoli, cauliflower, collards, mustard, and cabbage.
But don’t worry—we’ll have plenty of pansies, mixed pots, perennials, dianthus, and snapdragons to add some color and life to your fall gardens.
Stay tuned for more updates as we get closer to sale time—we can’t wait to see you at the greenhouse!




Our Pre-K students visited our Visual Arts Department recently and had fun making Viking hats. They will be study Leif Erikson, a Norse explorer who is thought to have been the first European to set foot on continental America, approximately half a millennium before Christopher Columbus soon.
How cute are they!
#TinyVikes
How cute are they!
#TinyVikes




CONGRATULATIONS to Samuel McLendon on being chosen as one of our September 2025 Employees of the Month for Academy of Craft Training. The Employee of the Month for this month was based on their performance in the classroom and the shop. This recognition is selected by the instructor for being “that student that stood out above the rest” by doing everything asked of them and then some.
Samuel’s instructor, Mr. Perry said that “Samuel is always prompt, on time, and ready to work. He played a vital role in getting all of our new students issued their PPE and getting set up in NCCER. He has assisted with the completion of countless projects around the campus with superior performance and minimal supervision. He sets the example on what the ACT program promotes for success. He will be an asset to any company he goes to work for”.
Samuel’s instructor, Mr. Perry said that “Samuel is always prompt, on time, and ready to work. He played a vital role in getting all of our new students issued their PPE and getting set up in NCCER. He has assisted with the completion of countless projects around the campus with superior performance and minimal supervision. He sets the example on what the ACT program promotes for success. He will be an asset to any company he goes to work for”.


Congrats to Miquel Kidd & Ja’kyron Blount for qualifying in SMAW (Shielded Metal Arc Welding) earning their AWS 3G Certification. They are currently in the Welding Program at Faulkner Career Tech Center.

Parents, you are invited to "Doughnuts with Diaz" on Tuesday, October 21, 2025 to kick off National Parenting Week! Mr. Diaz will be available to share his thoughts on topics that are a part of his vision for the school as well as a Q & A session. The meeting will be held in the Collab Lab from 9:15 - 9:45 A.M. We look forward to seeing you there!

Mrs. Peoples-Williams’ Physics students put science in motion during an AMSTI lab! 🚗💨 Using toy cars, they tested velocity, collected data, and applied real-world problem-solving skills. Hands-on learning like this makes physics come alive, helping students see the connection between classroom concepts and everyday motion.








Big day in ag class—tractor driving lessons!
From figuring out the gears to making those wide turns, Viking Horticulture students are learning hands-on skills that stick with them far beyond the classroom. Nothing like the first time behind the wheel of a tractor—it’s a little nerve-wracking, a lot of fun, and 100% unforgettable.
#AgClass #HandsOnLearning #TractorTime #PerserverancePropelsProgress #HandsOnLearning
From figuring out the gears to making those wide turns, Viking Horticulture students are learning hands-on skills that stick with them far beyond the classroom. Nothing like the first time behind the wheel of a tractor—it’s a little nerve-wracking, a lot of fun, and 100% unforgettable.
#AgClass #HandsOnLearning #TractorTime #PerserverancePropelsProgress #HandsOnLearning






Students in Mrs. McNellage's Visual Arts class have created several projects this year. They started out the year by taking it wayyyyy back and creating MySpace profiles. Such nostalgia for those that remember one of the first social media sites. Next they worked on Zentangle drawings. A Zentangle drawing is an abstract piece of art created using a structured method of repetitive patterns, called "tangles," within a confined space. This meditative technique, developed by Rick Roberts and Maria Thomas, emphasizes the creative process over a perfect outcome, using simple lines, curves, and shapes to foster relaxation, focus, and mindfulness.






Volunteers needed! Sign up today to help our senior students!
Mock Interviews: https://moretomobileal.volunteerlocal.com/volunteer/?id=91433&job_name=mary%20g.%20montgomery%20high%20school%20mock%20interviews
Resume Workshop: https://moretomobileal.volunteerlocal.com/volunteer/?id=104484&job_name=mary%20g.%20montgomery%20high%20school%20resume%20workshop
Mock Interviews: https://moretomobileal.volunteerlocal.com/volunteer/?id=91433&job_name=mary%20g.%20montgomery%20high%20school%20mock%20interviews
Resume Workshop: https://moretomobileal.volunteerlocal.com/volunteer/?id=104484&job_name=mary%20g.%20montgomery%20high%20school%20resume%20workshop

